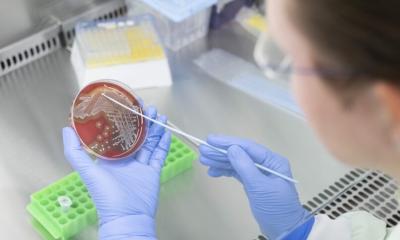

Quelle: University of California, San Francisco
News • Eigen und doch fremd
Warum das Immunsystem patienteneigene Stammzellen bekämpft
Induzierte pluripotente Stammzellen, kurz iPSC, sind ein vielversprechender Weg, den Mangel an menschlichen Spenderorganen zu überwinden. Denn wie embryonale Stammzellen sind iPSC in der Lage, sich in jede beliebige Körperzelle zu verwandeln. Professor Dr. Sonja Schrepfer, Wissenschaftlerin des Deutschen Zentrums für Herz-Kreislauf-Forschung (DZHK) am Universitätsklinikum Hamburg-Eppendorf, und ihr Team haben nun herausgefunden, dass sich die Stammzellen genetisch verändern, während sie im Labor zum gewünschten Zelltyp heranwachsen. Beim anschließenden Einsetzen des neu gezüchteten Zellgewebes zurück in den Patienten stößt dessen Immunsystem sie deshalb ab.
iPSC entstehen aus Körperzellen, zum Beispiel Hautzellen, die Ärzte dem Patienten entnehmen, anschließend im Labor zu Stammzellen reprogrammieren und zu dem gewünschten Zelltyp weiter züchten. Im Labor entwickeln Wissenschaftler aus ihnen etwa neue Herzmuskelzellen, um damit ein Infarkt-geschädigtes Herz zu reparieren. Verglichen mit embryonalen Stammzellen weisen iPSC einige Vorteile auf: Zum einen sind sie ethisch unbedenklich und ihre Entnahme birgt auch keinerlei Risiken für den Zellspender. Zum anderen nahmen die Forscher bislang an, dass der Körper des Patienten die neuen, aus iPSC gezüchteten Zellen gut akzeptiert, denn eigentlich kennt er sie ja schon. Tatsächlich stößt er das neue Gewebe aber trotzdem häufig ab. Schrepfer und ihr Team haben nun herausgefunden, dass dafür Veränderungen in der Erbinformation der Zellen verantwortlich sind. Sie entstehen, wenn Forscher die entnommenen Körperzellen im Labor reprogrammieren und kultivieren. Diese als Mutationen bezeichneten Veränderungen der Erbinformation wandeln die Zellen so um, dass das Immunsystem sie als fremd ansieht und bekämpft, wenn das aus ihnen gezüchtete Zellgewebe wieder in den Patienten eingesetzt wird.
An sich sind solche Mutationen nichts Ungewöhnliches und ereignen sich auch normalerweise im Körper. Doch dort beseitigt das Immunsystem die veränderten Zellen sofort und sorgt somit dafür, dass sie sich nicht anreichern können. Diese Kontrolle fehlt im Labor, sodass sich auch genetisch veränderte Zellen immer weiter vermehren.
Akzeptanz durch Tarnung
Als Konsequenz müssten die Patienten nach einer Transplantation von Gewebe aus iPSC lebenslang Medikamente einnehmen, die eine Immunantwort unterdrücken, sogenannte Immunsuppressiva. Sie verhindern zwar die Abstoßung, verursachen aber auch beträchtliche Nebenwirkungen. Unter anderem schädigen Immunsuppressiva Nieren und Leber und erhöhen das Risiko für Tumoren sowie Diabetes. „Alternativ könnte man den Zellen eine Art Tarnkappe geben“, sagt Schrepfer. „Damit gaukelt man dem Körper des Patienten vor, dass die im Labor hergestellten Zellen seine eigenen sind, sodass sie nach der Transplantation nicht mehr abgestoßen werden.“ Diese von Schrepfer und ihren Kollegen bereits entwickelte Tarnkappen-Technologie überprüfen die Wissenschaftler zurzeit intensiv. In Modellversuchen hat das Verfahren schon funktioniert. Die Medizinerin schätzt, dass sie die Technologie in fünf bis acht Jahren bei Patienten einsetzen können. Eine andere Strategie wäre, dass nur Zellen transplantiert werden, die nicht mutiert sind. Solch eine Qualitätskontrolle wäre laut Schrepfer aber sehr zeit- und kostenaufwendig.
Quelle: Deutsches Zentrum für Herz-Kreislauf-Forschung e.V.
17.09.2019